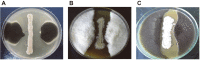
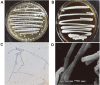

Rhizospheric-Derived Nocardiopsis alba BH35 as an Effective Biocontrol Agent Actinobacterium with Antifungal and Plant Growth-Promoting Effects: In Vitro Studies
- PMID: 36864500
- PMCID: PMC10236170
- DOI: 10.4014/jmb.2301.01001
Rhizospheric-Derived Nocardiopsis alba BH35 as an Effective Biocontrol Agent Actinobacterium with Antifungal and Plant Growth-Promoting Effects: In Vitro Studies
Abstract
The biocontrol approach using beneficial microorganisms to control crop diseases is becoming an essential alternative to chemical fungicides. Therefore, new and efficient biocontrol agents (BCA) are needed. In this study, a rhizospheric actinomycete isolate showed unique and promising antagonistic activity against three of the most common phytopathogenic fungi, Fusarium oxysporum MH105, Rhizoctonia solani To18, and Alternaria brassicicola CBS107. Identification of the antagonistic strain, which was performed according to spore morphology and cell wall chemotype, suggested that it belongs to the Nocardiopsaceae. Furthermore, cultural, physiological, and biochemical characteristics, together with phylogenetic analysis of the 16S rRNA gene (OP869859.1), indicated the identity of this strain to Nocardiopsis alba. The cell-free filtrate (CFF) of the strain was evaluated for its antifungal potency, and the resultant inhibition zone diameters ranged from 17.0 ± 0.92 to 19.5 ± 0.28 mm for the tested fungal species. Additionally, the CFF was evaluated in vitro to control Fusarium wilt disease in Vicia faba using the spraying method under greenhouse conditions, and the results showed marked differences in virulence between the control and treatment plants, indicating the biocontrol efficacy of this actinomycete. A promising plant-growth promoting (PGP) ability in seed germination and seedling growth of V. faba was also recorded in vitro for the CFF, which displayed PGP traits of phosphate solubilization (48 mg/100 ml) as well as production of indole acetic acid (34 μg/ml) and ammonia (20 μg/ml). This study provided scientific validation that the new rhizobacterium Nocardiopsis alba strain BH35 could be further utilized in bioformulation and possesses biocontrol and plant growth-promoting capabilities.
Keywords: Nocardiopsis alba BH35; Rhizosphere; antifungal; biocontrol; plant growth-promoting.
Conflict of interest statement
The authors have no financial conflicts of interest to declare.
Figures

References
-
- Oerke EC. Crop losses to pests. J. Agric. Sci. 2006;144:31–43. doi: 10.1017/S0021859605005708. - DOI
-
- Rani L, Thapa K, Kanojia N, Sharma N, Singh S, Grewal AS, et al. An extensive review on the consequences of chemical pesticides on human health and environment. J. Clean. Prod. 2021;283:124657. doi: 10.1016/j.jclepro.2020.124657. - DOI
-
- Bhardwaj T, Sharma JP. Impact of pesticides application in agricultural industry: an Indian scenario. Int. J. Agric. Food Sci. Technol. 2013;4:2249–3050.
-
- Hamblin JD. Pick your poison Banned: a history of pesticides and the science of toxicology Frederick Rowe Davis Yale University Press, 2014. pp. 284. Science. 2015;347:1208. doi: 10.1126/science.aaa3383. - DOI
-
- Laxmishree C, Nandita S. Botanical pesticides, a major alternative to chemical pesticides: a review. Int. J. Life Sci. 2017;5:722–729.
MeSH terms
Substances
Supplementary concepts
LinkOut - more resources
Full Text Sources
Miscellaneous